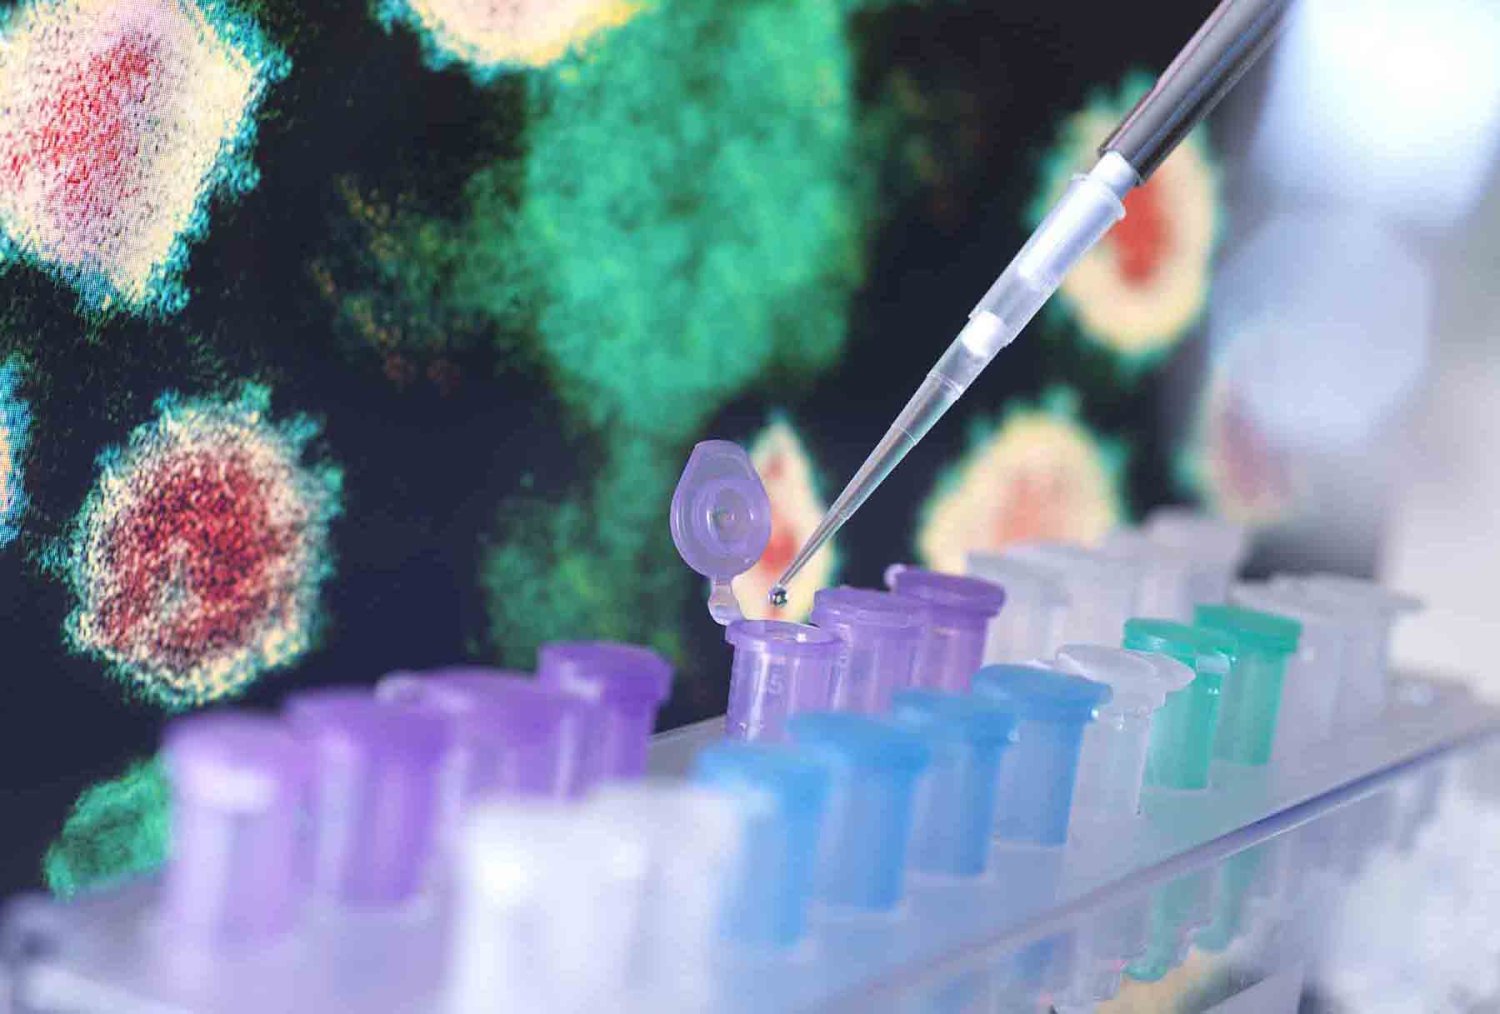
quienes desarrollan las vacunas

Cargando

La carrera de Química Farmacéutico Biólogo se define como un abanico de posibilidades con conocimientos para enfrentar los retos de salud del presente.
Las vacunas las desarrollan un grupo de expertos, donde los químicos farmacobiólogos juegan un importante papel.
Seguramente en los últimos días has escuchado mucho sobre la importancia de vacunarse contra el sarampión, o también recuerdas que hace 5 años gran parte de la población se tuvo que vacunar contra el Covid-19, pero ¿sabes quiénes y cómo se desarrollan las vacunas?
Es importante mencionar que el desarrollo de vacunas está a cargo de científicos, los cuales se encargan de diseñar, desarrollar y poner a prueba las vacunas. Precisamente, entre ese grupo profesionales se encuentran los egresados de la carrera de Químico Farmacéutico Biólogo.
Los químicos farmacobiólogos poseen un conocimiento profundo sobre los patógenos que causan diversas enfermedades, así como sobre su mecanismo de entrada al organismo y los daños que estos provocan.
El conocimiento de estos expertos es muy amplio y necesario para el desarrollo de medicamentos y vacunas, explicó la Dra. Dania Olivia Govea Alonso, Profesora-Investigadora de la Universidad Autónoma de Guadalajara (UAG).
¡Conoce nuestra oferta educativa!
¿Cuál es el proceso para crear las vacunas?
“Gracias a esta formación, los químicos farmacobiólogos diseñan vacunas enfocadas en limitar la acción de agentes infecciosos como el virus del sarampión”, afirmó la académica.
“El proceso de creación incluye evaluaciones rigurosas en distintos niveles; primero realizan pruebas a nivel laboratorio y posteriormente efectúan evaluaciones preclínicas con animales para verificar que la posible vacuna fuera segura y eficaz”.
Una vez que el personal aprueba estos estándares, la vacuna pasa a fases de evaluación en humanos, primero con sujetos sanos y después con pacientes afectados por la enfermedad.
El papel de estos profesionales resulta fundamental desde la etapa del diseño, donde determinan si el “biológico” contendrá partes del patógeno o el microorganismo completo.
¿Te gustaría estudiar esta carrera?
Compártenos tus datos.
Asimismo, ellos seleccionan las moléculas adicionales que acompañarán a la vacuna para asegurar una administración adecuada en los seres humanos, explicó la Dra. Govea Alonso.
En el ámbito del diagnóstico, los especialistas identifican al patógeno y determinan su incidencia en la población para enfrentar los problemas de salud con precisión.

El conocimiento de los QFB es fundamental en la creación de medicamentos y vacunas.
QFB, una carrera de gran valor
La académica de la UAG destacó que, durante situaciones de epidemias o pandemias, los químicos farmacobiólogos trabajan en conjunto con médicos epidemiólogos e internistas, entre otros expertos de la salud.
“En estas colaboraciones, el químico farmacobiólogo también tiene la responsabilidad de determinar la cantidad de dosis necesarias para proteger a la población y programar la distribución estratégica de las vacunas durante los brotes”, apuntó la académica de la UAG.
Por ello, la Dra. Govea Alonso detalló que los QFB son especialistas necesarios para la atención de la salud pública, quienes también tiene la tarea de actualizarse constantemente para fortalecer la respuesta ante nuevas crisis sanitarias.


Esto, como parte de la materia de Técnicas de Representación.


El evento contó con la participación de académicos, estudiantes de la UAG y profesionales destacados del sector salud mental que hablaron sobre los retos actuales de esta profesión.


Con acceso a rutas de certificación de Oracle Academy y Oracle University, este espacio impulsa la formación técnica y estratégica de futuros profesionales en un contexto digital sin fronteras.


Colaboradores exploraron de cerca los espacios donde se desarrollan soluciones tecnológicas y científicas que impulsan el futuro institucional.